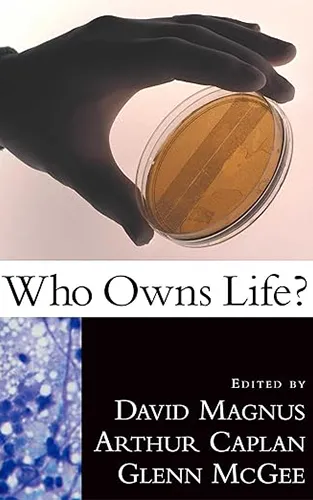

Books by Advisory Board Members
Click to learn about a book. Swipe to change direction. View full list of books!
Biology
- Out of the Past: A new species of Tantilla of the calamarina group (Squamata: Colubridae) from southeastern coastal Guerrero, Mexico, with comments on relationships among members of the group
- coauthored by Lydia Allison Fucsko – 2022
Futurism
- The Cake and The Table: Systems Thinking for the 21st Century
- by Frank D. Smith – 2023
- The Existential Risk of Failing to Build Democratic Power
- by Ahmed Bouzid – 2025
- The Final Frontier of Human Innovation
- by Ahmed Bouzid – 2025
- The Great Convergence
- by Ahmed Bouzid – 2025
- It is Time for the Two-Swarm Movement
- by Ahmed Bouzid – 2025
- On Weapons of Mass Surveillance
- by Ahmed Bouzid – 2025
Human Trajectories
- Calamities causing loss of museum collections: a historical and global perspective on museum disasters
- coauthored by Lydia Allison Fucsko – 2023